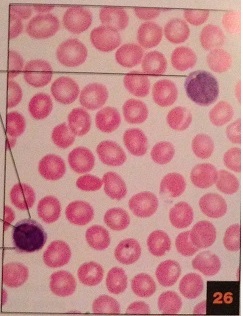

simple squamous epithelium: mesothelium

simple squamous epithelium:renal corpuscle
simply cuboidal epithelium:renal medulla

simple columnar epithelium:small intestine

simple columnar epithelium : oviduct

pseudostratified columnar epithelium:trachea

stratified squamous epithelium: mucosa of the esophagus

stratified cuboidal epithelium :duct of sweat gland

stratified columnar epithelium: duct in parotid gland

transitional epithelium: ureter

areolar connective tissue

adipose tissue: external ear

reticular conective tissue: lymph node

dense irregular connective tissue: submucosa of large intestine

dense regular connective tissue:tendon

elastic connective tissue: aorta

hyaline cartilage connective tissue:trachea

elastic cartilage connective tissue:epiglottis and external ear

fibrocartilage connective tissue:tendon

compact bone connective tissue

spongy bone

blood smear

blood smear: basophil
blood smear:lymphocyte